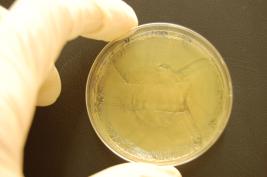
Control
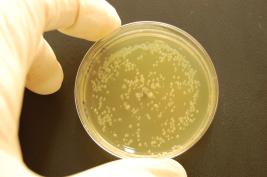
Ozone 1 * 24 sec. (immediate)
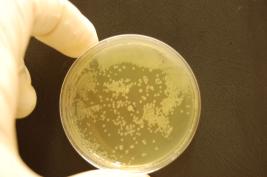
Ozone 1 * 24 sec. (after 1,5h)
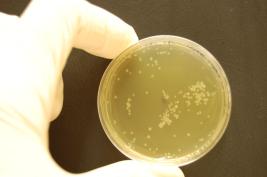
Ozone 3 * 24 sec. (after 1,5 h)
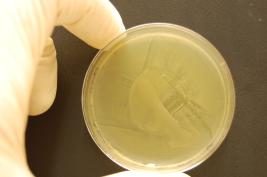
Control
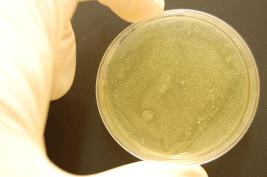
Ozone 1 * 24 sec. (after 1,5 h)
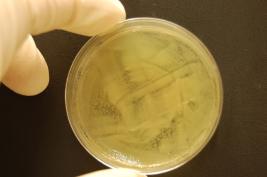
Ozone 1* 24 sec. (immediate)
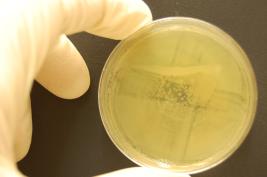
Ozone 1* 24 sec. (after 1,5 h)
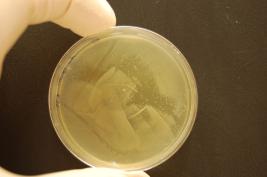
Ozone 1 * 24 sec. (immediate)

Inactivation of bacteria using W&H Prozone
The effectiveness of Prozone, the ozone generator from W&H, was tested in a study carried out by Dr Kristjan Plätzer (university lecturer), Corina Dallinger (B. rer. nat./BSc Natural Sciences) and Prof. Barbara Krammer in the Department of Molecular Biology at Salzburg University in Austria. First study results have been published already in March 2010 in the Dental Tribune.
Study details
Objective
The objective of the study was to test the effectiveness of ozone treatment using W&H Prozone and Endo tips.
Structure of the study
Effectiveness was tested on two model organisms, the Gram-positive bacterium Streptococcus mutans and the Gram-negative bacterium Escherichia coli, as representatives of the two bacterial groups. In order to evaluate the question, an experiment was carried out on agar plates (diameter of 6 cm). In this experiment, the test subjects were separated into two groups: samples that were immediately treated without allowing bacteria to grow (labelled as “immediate”) and samples that were treated after bacteria cells were allowed to multiply in the growth medium for 1.5 hours (labelled as “after 1.5 hr”).
In all experiments, the effectiveness of ozone was tested when gassing for 24, 3*24, 5*24 and 7*24 seconds. The control samples were not gassed.
Results
The experiments conducted indicate that immediate 24-second ozone treatment has visible effects on both bacterial strains (E. coli and S. mutans). If bacteria are allowed to grow for 1.5 hours, visible effects on treated areas are less significant throughout. Nevertheless, areas with a reduced bacterial count are generated. When the duration of the treatment is increased, the areas which contain no bacteria or have a low bacterial count also increase.
Treatment of agar plates with bacterial strain E. coli

When gassed for more than 24 seconds, larger bacteria-free areas are measurable, in which only individual colony-forming bacteria remain. An example of this effect is presented here. The sample was gassed for a duration of 3*24 sec.

Treatment of agar plates with bacterial strain
S. mutans

When gassed for more than 24 seconds, larger bacteria-free areas are measurable, in which only individual colony-forming bacteria remain. An example of this effect is also presented here. The sample was gassed for a duration of 3*24 sec.


W&H generally recommends replacing the air filter cartridge integrated in the device after approximately 500 uses. Further experiments were conducted in order to test the effectiveness of ozone treatment after 500 uses.
Treatment of agar plates with bacterial strain E. coli
with old air filter cartridge

Treatment of agar plates with bacterial strain
S. mutans with old air filter cartridge

Even when using old air filter cartridges, gassing for 24 seconds still results in bacteria-free areas. With old air filter cartridges, immediate treatment without allowing bacteria to grow (labelled as “immediate”) is again marginally more effective than treatment after bacteria cells were allowed to multiply in the growth medium for 1.5 hours (labelled as “after 1.5 hr”).
Interpretation of results
All experiments showed areas with a reduced bacterial count when treated for 24 seconds. Because in dentistry ozone is applied at specific points and the average size of a molar is small at approximately 5.8 mm, the bactericidal effect of a 24-second treatment is considered to be effective. It is essential to note that the condition of the air filter cartridge has a significant impact on the bactericidal effect of ozone treatment.
comments